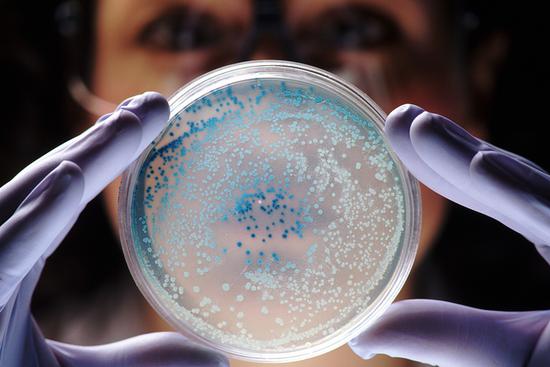

告別了錘子科技和“小野”,久未露面的羅永浩來著一個(gè)鮮為人知的“黑科技”——鯊紋抗菌技術(shù),在北京工業(yè)大學(xué)奧林匹克體育館開了一個(gè)叫2019“老人與海”的大型發(fā)布會(huì)。

鯊紋技術(shù)的靈感來自于鯊魚可以常年在大海中不受細(xì)菌和微生物的影響這一現(xiàn)象。“鯊紋”這項(xiàng)專利技術(shù)雖然最早由美國(guó)佛羅里達(dá)大學(xué)材料工程學(xué)教授布倫南發(fā)明,并在2004年提交發(fā)明專利的方式面世。但是,對(duì)于普羅大眾來講,“鯊紋”還是一個(gè)陌生詞匯。
其實(shí),“鯊紋”是Sharklet技術(shù)的中文譯名。簡(jiǎn)單來講,這是一種仿生學(xué)物理抗菌方式,模擬鯊魚皮膚排布,通過改變材料表面紋路/紋理以達(dá)到抗菌目的。

詳細(xì)來講,鯊紋抗菌的技術(shù)原理有三:第一,鯊紋材料可以“疏水疏油”,避免給細(xì)菌滋生提供良好的溫床;第二,鯊紋材料的結(jié)構(gòu)間隙可以減少皮膚和細(xì)菌的直接接觸;第三,鯊紋材料2微米的結(jié)構(gòu)間隙剛好是常見細(xì)菌的單個(gè)體型大小,因此不利于細(xì)菌集群,從而減緩細(xì)菌的分裂繁殖。

從上述的鯊紋抗菌的技術(shù)原理來看,它最大的特點(diǎn)就是可通過物理的方式抗菌,從而避免化學(xué)除菌導(dǎo)致的“超級(jí)細(xì)菌”。并且由于是物理抗菌,所以可以不分細(xì)菌類別的達(dá)到統(tǒng)一的抗菌效果。

而據(jù)羅永浩在發(fā)布會(huì)上的介紹我們得知:鯊紋抗菌材料有著廣泛的應(yīng)用場(chǎng)景,包括醫(yī)療、公共、生活、餐飲、母嬰等等領(lǐng)域的塑膠件都是這種材料絕佳的試驗(yàn)田。其中,醫(yī)療是其重點(diǎn)商業(yè)化的領(lǐng)域,比如導(dǎo)尿管。另外,Sharklet還有奶嘴、瑜伽毯應(yīng)用場(chǎng)景等。而羅永浩本人更是拓寬了它的使用場(chǎng)景,推出了抗菌兒童背包、抗菌鋁鎂商務(wù)旅行箱等。

這些聯(lián)想給我們提供了想象空間的同時(shí),也招來了質(zhì)疑:這項(xiàng)技術(shù)真的可以這么神奇應(yīng)用?
首先推翻這個(gè)可能性的是醫(yī)學(xué)界專業(yè)人士——丁香園。12月4日,丁香園發(fā)布了一篇文章《用了抑菌材料做的背包,就不會(huì)感染疾病嗎?可能對(duì)細(xì)菌有些誤解……》探討了抑菌材料的功效。除此以外,丁香園首先強(qiáng)調(diào)抑菌不等于殺菌,微生物也并不一定需要接觸才能傳播。其次,抑菌材料已經(jīng)應(yīng)用于醫(yī)療領(lǐng)域,但大多為一次性使用產(chǎn)品,而生活化場(chǎng)景中的物品往往是反復(fù)使用的。在日常生活的長(zhǎng)期暴露,就意味著接觸充滿灰塵、顆粒、液體的環(huán)境,這些都會(huì)影響材料的表面屬性和材料功能的可能性。

而且,丁香園也提醒道:“就算用了抑菌材料做的書包,如果真的遇到病原體感染,該病還是會(huì)病的。真的生病了,也記得趕緊去醫(yī)院看病遵醫(yī)囑治療,可別聽人瞎說……”丁香園的質(zhì)疑、提醒說明羅永浩在發(fā)布會(huì)上講的很可能是把鯊紋抗菌技術(shù)的作用夸大,從而起到炒作的作用。很可能也是重復(fù)之前的操作——“忽悠”大眾。
讓我來細(xì)細(xì)分析一下,首先,鯊紋技術(shù)可以應(yīng)用到家電領(lǐng)域,例如冰箱內(nèi)部等。使用了鯊紋抗菌技術(shù)的冰箱內(nèi)部,理想狀態(tài)下的結(jié)果是,冰箱內(nèi)部的細(xì)菌減少。但是,實(shí)際情況是:但市面上,我們可以購(gòu)買的冰箱自身也有空氣凈化系統(tǒng),而且在低溫下細(xì)菌本來就繁殖緩慢,這時(shí)候如果應(yīng)用上了鯊紋抗菌技術(shù),是不是就顯得非常雞肋呢?

除了,冰箱內(nèi)部,鯊紋抗菌技術(shù)還可以應(yīng)用于電視遙控,但是就跟鯊紋手機(jī)殼一樣,刻印在產(chǎn)品表面上的鯊紋技術(shù)可能容易被磨損掉。所以,雖然我們剛購(gòu)買的時(shí)候,這項(xiàng)技術(shù)是挺有效的。但是,隨著我們使用的時(shí)間越來越長(zhǎng),這項(xiàng)技術(shù)的作用就越來越不明顯了。
回到了這個(gè)技術(shù)本身,雖然2004年教授布倫南就已經(jīng)提交發(fā)明專利,但在十多年間,即便融資做出過樣板片,由于在美國(guó)缺少將這種材料降低成本并商業(yè)化的供應(yīng)鏈,因而鯊紋技術(shù)的商業(yè)化和普及仍然困難重重。到了2017年左右,Sharklet被杭州的Peaceful Union收購(gòu)。經(jīng)歷了這么重重的波折,是否可以說明,這項(xiàng)技術(shù)的無法落地是大多數(shù)投資者對(duì)于其實(shí)際意義以及其未來前景的不樂觀?這仍然是一個(gè)問號(hào),我們可以保留這個(gè)可能性。

總的來講,鯊紋技術(shù)的潛力是巨大的,如果真的可以實(shí)現(xiàn)商用,達(dá)到理想效果,它可以為人類的健康創(chuàng)造很高的價(jià)值。但社會(huì)的認(rèn)可,產(chǎn)品的成熟,市場(chǎng)的拓展,還是現(xiàn)需潛下心來,一步一步啃的。目前羅永浩正致力于鯊紋技術(shù)的市場(chǎng)推廣,希望能推動(dòng)更多企業(yè)采用鯊紋技術(shù),促進(jìn)技術(shù)盡快落地商用。但是這場(chǎng)發(fā)布會(huì)并不算成功,現(xiàn)場(chǎng)的掌聲和笑聲都稀稀拉拉,遠(yuǎn)不如以往熱烈。發(fā)布會(huì)結(jié)束后,許多觀眾對(duì)羅永浩開啟了冷嘲熱諷模式。
有人表示對(duì)羅永浩已經(jīng)徹底失望;有人嘲諷稱,羅永浩終于成功找到適合自己的商業(yè)模式——為不同的公司站臺(tái)營(yíng)銷;更有人吐槽稱,整場(chǎng)發(fā)布會(huì)就是老羅個(gè)人的“直播帶貨”,“99.9%抑菌”的營(yíng)銷話術(shù)宛如當(dāng)年的舒膚佳……由此來看,這次羅永浩的“忽悠”效果好像不大。
雖然不被看好,這系列的鯊紋技術(shù)產(chǎn)品其實(shí)早已經(jīng)進(jìn)入市場(chǎng)。但對(duì)于消費(fèi)者來講,就像燚智能周教授點(diǎn)評(píng)這次發(fā)布會(huì)那樣:這次應(yīng)該算是個(gè)很成功的營(yíng)銷。哪怕大廠不care,大把的中小型公司靠這個(gè)當(dāng)賣點(diǎn)呢!至于為什么能抗菌、抗菌效果怎么樣,吃瓜群眾既看不出來也感覺不到。
站在消費(fèi)者的角度來想,我們會(huì)不會(huì)為了一種看不到、摸不著、心里沒底的技術(shù)來花錢?相信大部分消費(fèi)者是不會(huì)的,它不像是商業(yè)保險(xiǎn)、HPV疫苗等,對(duì)于消費(fèi)者來說鯊紋技術(shù)無疑是一種不可信的,假如一臺(tái)冰箱在原來的基礎(chǔ)上加入了鯊紋技術(shù),但售價(jià)卻提高30%,二者之間,孰輸孰贏估計(jì)大家心里都有答案了。
簡(jiǎn)而言之,這些普通消費(fèi)者難以察覺的“黑科技”,使用效果純屬靠吹。抱著寧可信其有,不可信其無的心理,普通的消費(fèi)者也會(huì)因?yàn)?ldquo;鯊紋技術(shù)”這個(gè)黑科技的加入,而購(gòu)買這些標(biāo)記了“鯊紋技術(shù)”字樣的產(chǎn)品。而羅永浩推出的這些“鯊紋技術(shù)”市場(chǎng)反響如何,只能等待市場(chǎng)銷量來驗(yàn)證了。
關(guān)鍵詞:
南海區(qū)西樵鎮(zhèn)攜手東方新蒙共建青年成才園 佛山新聞網(wǎng)訊珠江時(shí)報(bào)記者陳肖玲通...
【天天熱聞】禪城區(qū)召開2022年選調(diào)生基層鍛煉工作會(huì)議 佛山新聞網(wǎng)訊佛山日?qǐng)?bào)見習(xí)記者賀勇...
世界快看:第十三屆佛山車展擬下周開幕 實(shí)惠福利助力佛山車市年末再?zèng)_刺 佛山新聞網(wǎng)訊佛山日?qǐng)?bào)記者梁煒健報(bào)...
全球新消息丨遏制違法用地,禪城出臺(tái)“全鏈條”監(jiān)管措施 日前,禪城區(qū)人民政府辦公室印發(fā)了...